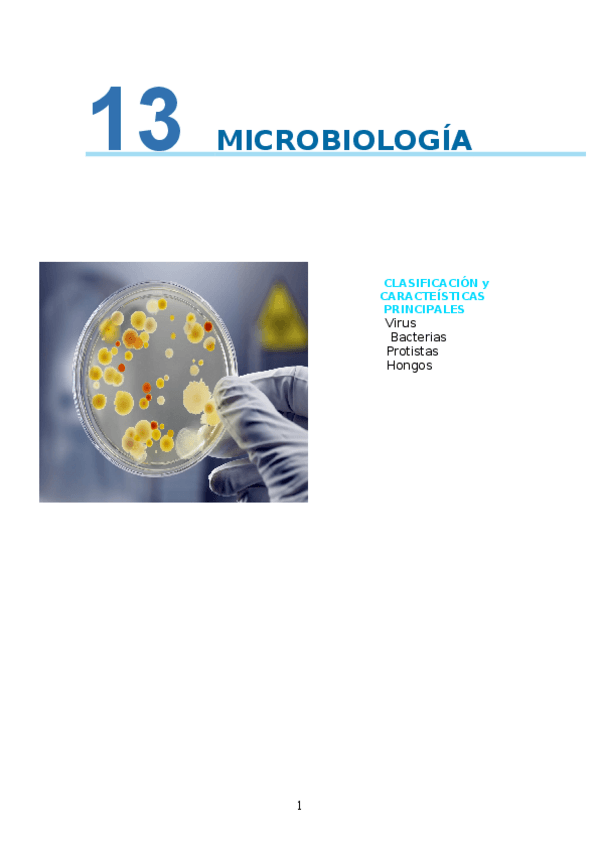

@user_4508598
46 Publicaciones
422 Interacciones
0 Seguidores
0 Siguiendo
Lista de publicaciones de user_4508598
He publicado nuevos apuntes de 1º Fisiopatología: definiciones-importantes.pdf
He publicado nuevos examenes de 1º Fisiopatología: examen-tipo-fisiopatologia.docx
He publicado nuevos examenes de 1º Historia, Teoría y Métodos de la enfermería I: EJEMPLO-PREGUNTAS-PARCIAL-3-HTMI.docx
He publicado nuevos ejercicios de 1º Fisiopatología: casos-clinicos-primer-parcial.pdf
He publicado nuevos apuntes de 1º Anatomía Humana: TABLA-CONDUCTO-GASTROINTESTINAL.pdf
He publicado nuevos apuntes de 1º Fisiología: tabla-glucagon-vs-insulina.pdf
He publicado nuevos apuntes de 1º Fisiología: tabla-clasificacion-de-hormonas.pdf
apuntes
-
ENFERMERIA PSICOSOCIAL
Faltan los temas 10 y 11 porque no los dimos
practicas
-
promoción de la salud
He publicado nuevos practicas de 1º Promoción de la Salud: promoción de la salud
He publicado nuevos apuntes de 2º Biología II: apuntes-metabolismo.Catabolismo23-24.pdf
He publicado nuevos apuntes de 2º Biología II: 6.-Evau-2025BLOQUE-FInmunologia-1.pdf
He publicado nuevos apuntes de 2º Biología II: Metabolismo-II-Anabolismo-1.pdf
He publicado nuevos apuntes de 2º Biología II: Tema-11.-Inmunologia-1.pdf
He publicado nuevos ejercicios de 2º Biología II: Ejercicios-de-mitosis-meiosis-division-celular.pdf
He publicado nuevos apuntes de 2º Historia de la Filosofía: Unidad-4.-Nietzsche.pdf
He publicado nuevos apuntes de 2º Lengua Castellana y Literatura II: IDENTIFICACION-DE-LAS-IDEAS-ORGANIZACION-Y-ESTRUCTURA-DEL-TEXTO-A-EMANCIPACION-POSTERGADA-17-ene-2025-a-las-1206.pdf
He publicado nuevos apuntes de 2º Lengua Castellana y Literatura II: LA-EXPRESION-DE-LA-SUBJETIVIDAD-Y-LA-OBJETIVIDAD-EN-LOS-TEXTOS-2020.pdf